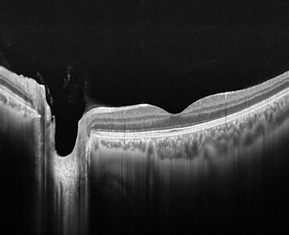
Background OCT 3.png

Patient Presentation: A 23-year-old obese female was diagnosed with idiopathic intracranial hypertension (IIH) and referred to neurosurgery for ventriculoperitoneal shunt. A baseline ocular examination was performed prior to the procedure.
On examination, vision was 20/200 in the right eye, and 20/40 in the left eye. There was a right relative afferent pupillary defect. Slit lamp examination was normal.
A dilated fundus examination was performed demonstrating the following:
The following section will provide you with a background to what Optical Coherence Tomography is.
What is OCT?
Optical coherence tomography (OCT) is a non-invasive diagnostic technique that utilizes light waves, or low coherence interferometry, to capture high resolution, cross-sectional images of the anterior and posterior segment of the eye. By obtaining scattered light rays from tissues in the eye, OCT can create spatial imaging of ocular structures.
OCT is particularly crucial in the management of macular diseases as it can image pathology (ex. edema, micro-aneurysms or neovascularization), and also reveal biomarkers (ex. disorganization of inner retinal layers) that impact treatment and prognosis.

Scan Acquisition
To obtain a quality OCT image, a minimum pupil diameter of 3mm is required. The technician chooses the correct scanning module and the area of interest. A real-time OCT image will appear to correct for patient refractive error. The patient will be instructed to look at a target for macular screening, or for an external marker if appropriate. The entry location of light through the pupil may be adjusted to produce the best signal in the image. Manual segmentation of retinal layers can be conducted, as well as manual measurement of thickness with intrinsic caliper functions. For all OCTs, the inner limiting membrane is the inner retinal border, whereas the outer retinal border can be modified based on the type of OCT machine and protocol chosen.
We will discuss two types of OCT (SD-OCT and SS OCT) in this section:
Spectral domain OCT (SD-OCT)
SD-OCT uses 20 000 – 70 000 A-scans per second to minimize artifact and increase resolution up to 3µm. It uses spectral interference pattern between reference beams and sample beams that are obtained simultaneously by a spectrometer and array detector. This allows for faster acquisition and higher quality images than older OCT technology
Advantages: High resolution (transverse resolution 14 – 20 µm)
Disadvantages: Poor penetrance, less width
Kishi S. Impact of swept source optical coherence tomography on ophthalmology. Taiwan Journal of Ophthalmology 2016;6(2):58-68.

Swept source OCT (SS-OCT)
SS-OCT is a more modified, depth-resolved technology that was recently released to allow for control of imaging depth, higher pathology detection efficiency, longer image range and improved penetrance of the choroid; however, the deeper penetrance trades off with a lower resolution. SS-OCT uses a narrow band of light swept through a wide range of frequencies
Advantages: Deeper penetrance, better choroid visualization, wider image range
Disadvantages: Less resolution (transverse resolution 20µm)
TEST YOUR KNOWLEDGE:
What type of OCT is shown on the right?
There are also various OCT scan protocols that are available. We will discuss each protocol briefly below:
1. Line: One cross sectional image on OCT and can be moved in various planes.
-
Refer to the location indicator to determine the particular plane
2. Radial: 6 - 12 line scans with an equal angle and single axis, where the center of the scan is the fovea by default.
-
Can see center of fovea to temporal arcades and posterior pole
-
Radial scans skip pathology outside of the fovea; don’t rely on radial alone
-
Very helpful for diseases like DME
Bhende M, Shetty S, Parthasarathy MK, Ramya S. Optical coherence tomography: A guide to interpretation of common macular diseases Indian Journal of Ophthalmology 2018;66(1):20-35.
3. Raster: Multiple line scans arranged in any plane for high resolution (horizontal or vertical)
-
One of the most essential to test macular pathology in various levels
-
Radial and raster are important for macular diseases
HD 5 Line Raster: The images depicted here are 5 horizontal line scans, as highlighted in the red box.
4. 3D Macular Map: Good for demonstrational purposes and to monitor change in retinal thickness. This can be a helpful tool in identifying edges of epi-retinal membrane or clinically significant macular edema. Thickness ranges are colour coded. (200 - 300µm blue, 300 - 400µm green, red > 500µm
-
Location of edema is not always accurate on topographic map
-
Can arrange 3D cube of macula
5. OCT Angiography: This will be discussed in another module




.png)